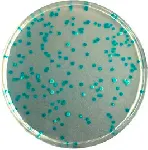

Products
Services
CHROMagar™ E. coli
Chromogenic dehydrated medium for detection and enumeration of E. coli in food and water samples.

Chromogenic dehydrated medium for detection and enumeration of E. coli in food and water samples.

Features
Scharlab S.L.
F +34937152765
helpdesk@scharlab.com
Gato Pérez, 33. Pol. Ind. Mas d’en Cisa E08181 Sentmenat, Barcelona, España
T +34937456400F +34937152765
helpdesk@scharlab.com
Laboratory supplies
Chemicals Microbiology Glassware, quartz and porcelain Chromatography Equipment Consumables Safety and hygiene
Chemicals Microbiology Glassware, quartz and porcelain Chromatography Equipment Consumables Safety and hygiene

 Rest of the World
Rest of the World